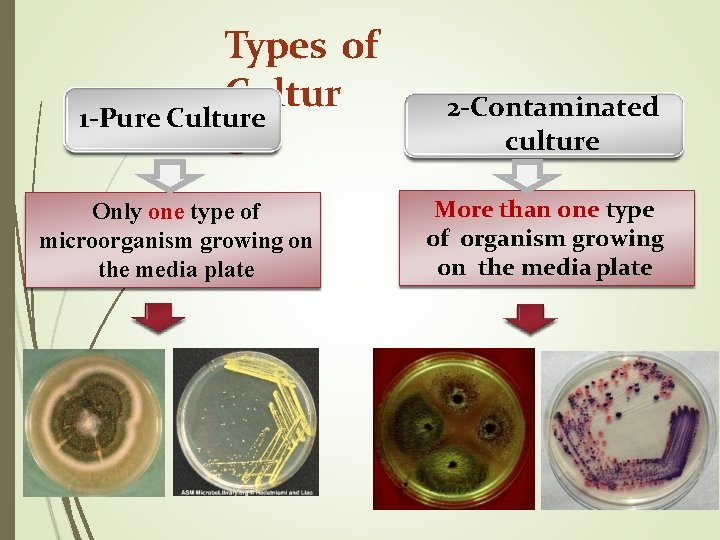
Types of Cultur 1 -Pure Culture e Only one type of microorganism growing on
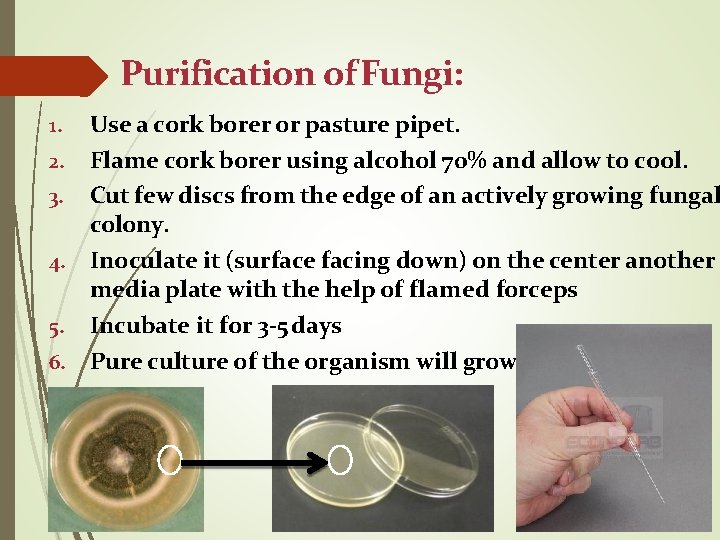
Purification of Fungi: Use a cork borer or pasture pipet. 2. Flame cork borer
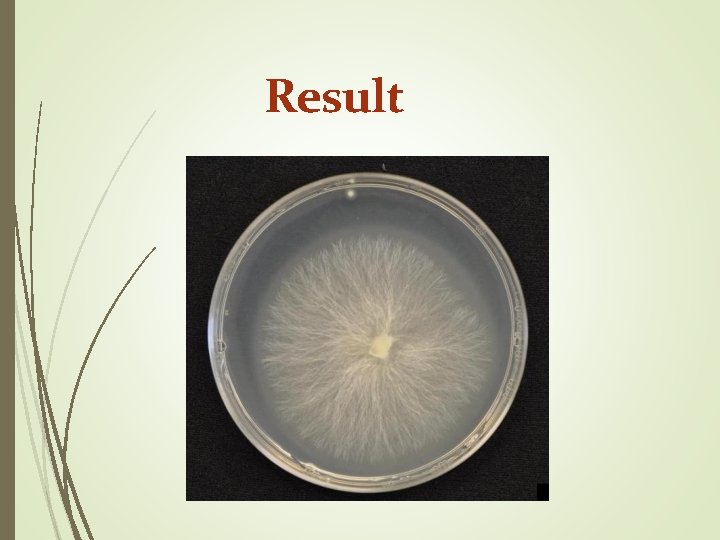
Result
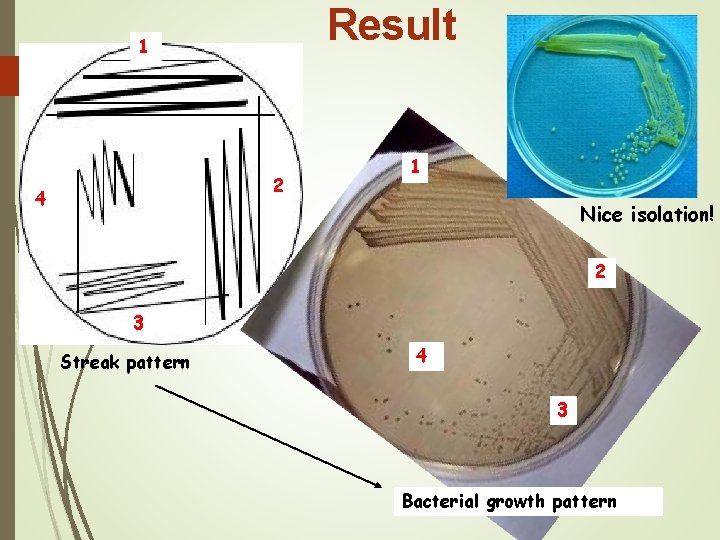
Result 1 2 4 1 Nice isolation! 2 3 Streak pattern 4 3 Bacterial
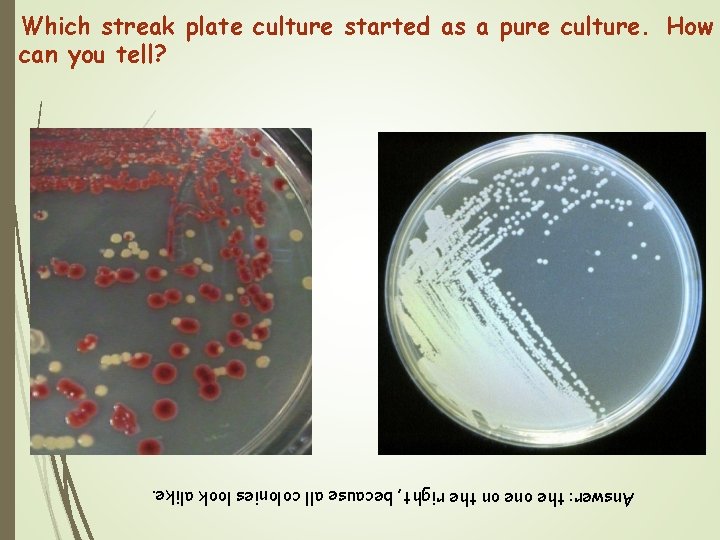
Which streak plate culture started as a pure culture. How can you tell? Answer:
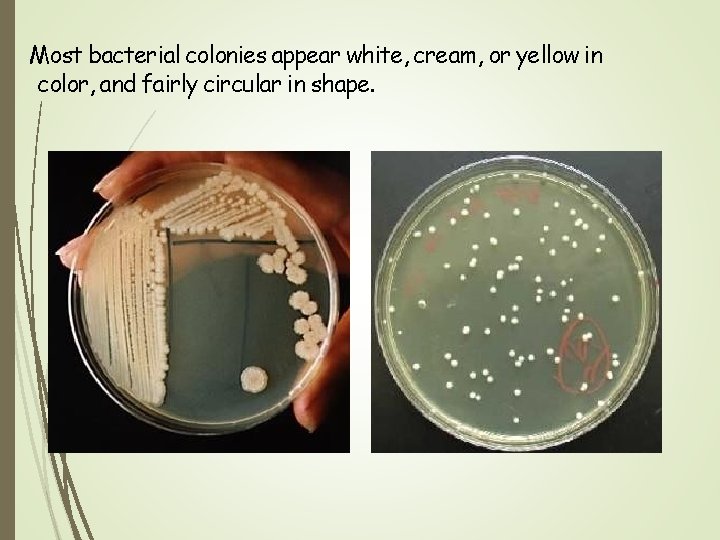
Most bacterial colonies appear white, cream, or yellow in color, and fairly circular in

140 MICRO LAB 5 PURIFICATION OF MICROORGANISM Culture

140 MICRO LAB 5 : PURIFICATION OF MICROORGANISM

�Culture The organism growing on the media plate is called as culture. �Colony The number of cells of any organism living together.
Types of Cultur 1 -Pure Culture e Only one type of microorganism growing on the media plate 2 -Contaminated culture More than one type of organism growing on the media plate

Purification of microorganism
Purification of Fungi: Use a cork borer or pasture pipet. 2. Flame cork borer using alcohol 70% and allow to cool. 3. Cut few discs from the edge of an actively growing fungal colony. 4. Inoculate it (surface facing down) on the center another media plate with the help of flamed forceps 5. Incubate it for 3 -5 days 6. Pure culture of the organism will grow. 1.
Result

Purification of Bacteria : Streak plate Method �Streak inoculum onto one portion of the plate �Sterilize the loop �Streak through the first inoculum and spread into second section �Repeat several times �Incubate it for 24 h. , a single colony will be observed.

Result 1 2 4 1 Nice isolation! 2 3 Streak pattern 4 3 Bacterial growth pattern
Which streak plate culture started as a pure culture. How can you tell? Answer: the on the right, because all colonies look alike.

Watch https: //www. youtube. com/watch? v=_1 KP 9 z. Otj. Xk

Characters of colony

Characters of colony � Form What is the basic shape of the colony? For example, circular, filamentous, etc. � Margin What is the magnified shape of the edge of the colony? � Elevation What is the cross sectional shape of the colony? Turn the Petri dish on end. � Surface How does the surface of the colony appear? For example, smooth, rough, dull , wrinkled etc. � Pigmentation For example, white, red, purple, etc.

Most bacterial colonies appear white, cream, or yellow in color, and fairly circular in shape.

Inoculated Agar Slant 1. Label the sterile nutrient agar slant with the source of the culture. 2. Sterilize the loop. 3. Remove a loopful of broth from the culture tube. 4. Insert the loop into the sterile agar slant tube and starting at the base of the slant, draw the loop up the slant. Do not penetrate the agar. Sterilize the loop. 5. Incubate the slant at 37 C for 24 -48 hours. 6. Observe the slant for growth.

Result Inoculated Agar Slant, after incubation

MORPHOLOGY ON SLANT AGAR

Liquid medium �In a liquid medium, the region in which the organism grows depends on the oxygen requirement of that particular species.

Liquid medium �*Turbid � *Pellicle ((thick growth at the top of the tube)) �*Sediment

How to characters of colony? https: //www. slideshare. net/Hiwr. Hastear/culturecharacteristic-of-bacteria

The End
- Slides: 22